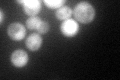
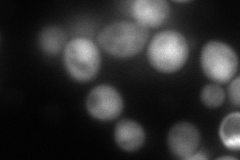
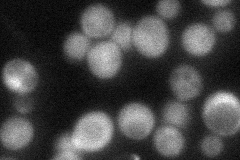
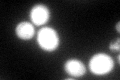

View description
Zn-ribbon protein that co-purifies with Dph1 and Dph2 in a complex required for synthesis of diphthamide on translation factor eEF2 and with Elongator subunits Iki3p, Elp2p, and Elp3p involved in modification of wobble nucleosides in tRNAs
Localization:
Intensity:
Fold change:
Significance:
-
C’ GFP library in SD
nucleus:cytosol89.02 -
N' NOP1pr-GFP in SD

cytosol107.838 -
N' TEF2pr-mCherry in SD
nucleus166.126 -
N' NATIVEpr-GFP in SD
cytosol,nucleus50.773 -
N' TEF2pr-VC and Cyto-VN in SD

cytosol50.9029 -
C’ GFP library in SD+DTT
nucleus.cytosol102.581.15No -
C’ GFP library in SD+H2O2

nucleus.cytosol91.721.03No -
C’ GFP library in Starvation Media

nucleus,cytosol75.580.84No -
C’ GFP library on the background of Pup2-DaMP

nucleus:cytosol -
C’ GFP library on the background of CCT mutant

nucleus:cytosol89.89111.00967No
